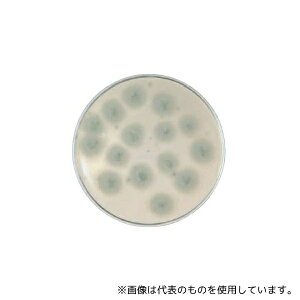
�x�N�g���E�f�B�b�L���\�� 252586 BD BBL(TM) �T�u���[�f�L�X�g���[�XLP���V�|�n RT 1��(1�{×100����)

「RT-1」の人気商品一覧 | 安い商品を通販サイトから探す
2,631件 1〜40件を表示- 価格の安い順
- 価格の高い順
- 検索条件:
- 計測用具
- 本ページでは掲載するECサイトやメーカー等から購入実績などに基づいて手数料を受領しています。

その他の計測用具
●トレイを積み重ねることで省スペース化でき、滅菌性を維持したまま、スムーズに詰替え作業ができます。●2139-HR詰め替え用●放射線滅菌済●入数:(96本*5トレイ)*2セット●ART●事業者向け商品です。リニューアルに伴い、パッケージ・内
この商品で絞り込む

その他の計測用具
●オートサンプラーバイアル●セプタム付スクリューキャップ●キャップサイズ:13-425●キャップ穴サイズ:8mm●キャップ材質:ポリプロピレン●キャップの色:黒●セプタムサイズ:12mm●セプタム:PTFE 透明/ ゴム赤●セプタムの...

その他の計測用具
ゴミの削減及び収納スペースの削減に適しています。※こちらは【取り寄せ商品】です。必ず商品名等に「取り寄せ商品」と表記の商品についてをご確認ください。
この商品で絞り込む

墨つぼ・チョーク・マーカー
※こちらの商品はご入金確認後のお手配です。代引きでのお取り扱いはできません。メーカー直送品となります。 高輝度グリーンレーザー【MGL-441GP】 指示方式:ジンバル機構 水平4方向・たて4方向・地墨 鉛直(クロスライン) 特徴 1...

その他の計測用具
●ラック入りピペットチップ●汎用チップ●汎用チップ リムーバブルカバーラック●フィルター滅菌済200μL●960本(10ラック)●※※事業者向け商品です※※
この商品で絞り込む

その他の計測用具
●トレイを積み重ねることで省スペース化でき、滅菌性を維持したまま、スムーズに詰替え作業ができます。●2070-HR詰め替え用●放射線滅菌済●入数:(96本*5トレイ)*2セット●ART●事業者向け商品です。リニューアルに伴い、パッケージ・内
この商品で絞り込む

その他の計測用具
PCR用キャップ付き8連チューブ 0.1mL フラットキャップ 60個×2袋入 PCR-8SAC-RT-1-C 1箱(60個×2袋入)●独立したキャップによりクロスコンタミを防ぎます。●連結部分が丈夫で...

温湿度計
【アズワン AS ONE】実験室設備 工具類 工具、道具 ●鉄筋コンクリート、御影石、大理石、ブロック、スレート、モルタル、レンガ、タイル等の切断に。 商品の仕様 ●メーカー:LENOX(レノックス) ●型番:LX4781 ●外径:1...

その他の計測用具
コード長さ(m):- 測定温度範囲(℃):-10~60 タイプ:一体型 測定範囲:-10~60℃ センサ部:PC 試験成績書 1部
この商品で絞り込む

その他の計測用具
【アズワン AS ONE】分析・特殊機器 分離・分析ロシ 分析機器その他 ●日本薬局方の微生物限度試験など用で、常温保存で6か月の有効期限です。 商品の仕様 ●生培地 ●3局対応 ●入数:100枚入 ●JANコード:382902524...
この商品で絞り込む

その他の計測用具
商品説明【特長】●海水、熱温水、蒸気等に長期にわたり耐え、腐食の少ない安定した材質です。【仕様】●品番:RT1/4x1/8●中心から端面までの距離L1(mm):19●中心から端面までの距離L2(mm):19●外径(mm)D1:19...

その他の計測用具
●型番:RT-1●材質:チューブ/ガラス(パイレックス(R))、プラグ/PTFE(四フッ化エチレン)●容量:1mL●胴径*全長*支管径:直径8*120*直径8mm●使用方法:チューブに試料を入れ、上部...
この商品で絞り込む

温湿度計
■SK-L700R-T用温度センサです【仕様】・測定温度範囲(℃): -10〜60・タイプ: 一体型・測定範囲: -10〜60℃セット内容●試験成績書 1部
この商品で絞り込む

その他の計測用具
【アズワン AS ONE】半導体関連機器 無塵対策商品 クリーンルームウェア 商品の仕様 ●用途:リストバンド ●カラー:オレンジ ●サイズ:38.1×177.8mm ●反射材:スコッチライト ●反射材幅:19mm ●反射材カラー:グ...
![エスコ [EA207RT-1用] ブレード EA207RT-11 入数:1個](https://tshop.r10s.jp/first34/cabinet/asone2-1/26/63320796.jpg?fitin=300:300)
温湿度計
【アズワン AS ONE】実験室設備 工具類 工具、道具 商品の仕様 ●EA207RT-1用替刃 ●刃幅:7.5mm ●刃先角度:90° ●入数:1枚 【※ご注意ください】商品は代表の画像を使用しています...

その他の計測用具
商品説明【特長】●海水、熱温水、蒸気等に長期にわたり耐え、腐食の少ない安定した材質です。【仕様】●品番:RT1-1/2x1-1/4●中心から端面までの距離L1(mm):45●中心から端面までの距離L2(mm):48...

墨つぼ・チョーク・マーカー
※こちらの商品はご入金確認後のお手配です。代引きでのお取り扱いはできません。メーカー直送品となります。 自動NAVIレーザー【MG-NV51】 指示方式:ジンバル機構 水平1方向・たて4方向・地墨 鉛直(クロスライン) 特徴 NAVI...

墨つぼ・チョーク・マーカー
納期目安:お取り寄せ品(詳しくはこちらをクリック) ※こちらの商品はメーカー直送品となります。※こちらの商品は代引きでのお取り扱いはできません。ご入金確認後のお手配です。 自動NAVIレーザー【MG-NV51】 指示方式:ジンバル機構 水

その他の計測用具
商品説明【特長】●海水、熱温水、蒸気等に長期にわたり耐え、腐食の少ない安定した材質です。【仕様】●品番:RT1x1/2●中心から端面までの距離L1(mm):32●中心から端面までの距離L2(mm):33●外径(mm)D1:44...

温湿度計
佐藤計量器製作所メーカーお問い合わせ:06-6944-0921【特長】●SK-L700R-T用温度センサです【仕様】●測定温度範囲(℃):-10〜60●タイプ:一体型【仕様2】●測定範囲:-10〜60℃【材質/仕上】●センサ部:PC【...
この商品で絞り込む
![アズワン AS ONE ミニ・バキュームチューブ RT-1 5-127-04 [1445-0104461]](https://tshop.r10s.jp/daishinshop/cabinet/item/1445-120/1445-0104461.jpg?fitin=300:300)
その他の計測用具
納期目安 (メーカーに在庫がある場合)13:30までにご注文の場合約3〜7日後出荷(土日祝日を除く)※表示の納期目安はあくまで目安ですのでお約束ではありません。具体的納期は都度お問い合わせください。お取り寄せ品です!ご注文後[商

その他の計測用具
【仕様】 ●適合機種:GP-501 ●こて先幅(mm):1 ●GP-501用替えこて先 【入数】 ●1個 他のサイズはこちら 在庫のない商品は検索に表示されない場合がございます
この商品で絞り込む

その他の計測用具
ゴミの削減及び収納スペースの削減に適しています。※こちらは【取り寄せ商品】です。必ず商品名等に「取り寄せ商品」と表記の商品についてをご確認ください。
この商品で絞り込む

その他の計測用具
太洋電機産業(goot) 替こて先 1D型 GP-510対応 1個●適合機種:GP-510●こて先タイプ:-●こて先径:φ1
この商品で絞り込む

その他の計測用具
【アズワン AS ONE】分析・特殊機器 分離・分析ロシ 分析機器その他 ●日本薬局方の微生物限度試験など用で、常温保存で6か月の有効期限です。 商品の仕様 ●生培地 ●3局対応 ●入数:100枚入 ●JANコード:382902524...
この商品で絞り込む

その他の計測用具
【アズワン AS ONE】実験室設備 工具類 研磨剤、研磨用品 ●錆取り、溶接後のスケール取り、メッキの下地研磨に。 ●軸が六角軸になっており、インパクトや電気ドリルでの使用が可能です。 商品の仕様 ●適用研磨物:鋼材、鋳物 ●最高使用
この商品で絞り込む

その他の計測用具
【アズワン AS ONE】半導体関連機器 無塵対策商品 クリーンルームウェア 商品の仕様 ●用途:リストバンド ●カラー:オレンジ ●サイズ:38.1×177.8mm ●反射材:スコッチライト ●反射材幅:19mm ●反射材カラー:グ...

温湿度計
【商品詳細】●SK-L700R-T用温度センサです●コード長さ(m):-●測定温度範囲(℃):-10〜60●タイプ:一体型●測定範囲:-10〜60℃材質/仕上●センサ部:PCセット内容/付属品●試験成績書 1部原産国台湾JANコード4...
この商品で絞り込む

その他の計測用具
【アズワン AS ONE】分析・特殊機器 分離・分析ロシ 分析機器その他 ●ロック機能付きガンマ線照射3重包装された局方対応の無菌エリア環境用スタンプです。 ●有効期限は9か月。 商品の仕様 ●生培地 ●3局対応 ●入数:100枚入 ...

その他の計測用具
【アズワン AS ONE】分析・特殊機器 分注・希釈・シリンジ ピペット用チップ ●ゴミの削減及び収納スペースの削減に適しています。 商品の仕様 ●材質:PP(ポリプロピレン) ●DNase・RNase・DNAフリー ●容量(μL):...
この商品で絞り込む

その他の計測用具
■ミニバキュームチューブ RT-1の特長 ●ペプチドや蛋白質の加水分解、試料濃縮、凍結乾燥、ヒドラジン分解時、高真空環境下での分析実験に最適な器具です。 ●容量(mL):1 ...

温湿度計
【アズワン AS ONE】物理・物性測定器 温度・湿度管理機器 温度・湿度管理関連機器 ●プラスチックのバリ取りや表面仕上げに最適です。 商品の仕様 ●全長:148mm ●刃先角度:90° ●1.7mm厚セラミックブレード ●刃幅:7...
この商品で絞り込む

その他の計測用具
【アズワン AS ONE】汎用器具・消耗品 金属・樹脂実験必需2 実験室必需用品、器具その他 ●Deutsch Connector工具 ●Deutsch 接器工具 商品の仕様 ●入数:1個 ●コンタクトタイプ:ピン、 ソケット ●コン...

その他の計測用具
【アズワン AS ONE】分析・特殊機器 分離・分析ロシ 分析機器その他 ●ロック機能付きガンマ線照射3重包装された局方対応の無菌エリア環境用スタンプです。 ●有効期限は9か月。 商品の仕様 ●生培地 ●3局対応 ●入数:100枚入 ...
この商品で絞り込む

その他の計測用具
【アズワン AS ONE】分析・特殊機器 分離・分析ロシ 分析機器その他 ●日本薬局方の製薬用水の品質管理に記載されています。 ●飢餓細菌、損傷菌の発育を促進します。 ●常温保存で6か月の有効期限です。 商品の仕様 ●生培地 ●局方対応
この商品で絞り込む

温湿度計
佐藤計量器製作所メーカーお問い合わせ:06-6944-0921【特長】●SK-L700R-T用温度センサです【仕様】●測定温度範囲(℃):-10〜60●タイプ:一体型【仕様2】●測定範囲:-10〜60℃【材質/仕上】●センサ部:PC【...
この商品で絞り込む

温湿度計
【商品詳細】 ●SK-L700R-T用温度センサです ●コード長さ(m):- ●測定温度範囲(℃):-10〜60 ●タイプ:一体型 ●測定範囲:-10〜60℃ 材質/仕上 <
この商品で絞り込む

その他の計測用具
トレイを積み重ねることで省スペース化でき、滅菌性を維持したまま、スムーズに詰替え作業ができます。
この商品で絞り込む

その他の計測用具
●ラック入りピペットチップ●LTSチップ●粘性の高いサンプルや表面張力の低い液体のピペッティングに最適●低吸着LTSチップ(リムーバブルカバーラック入)ローリテンションチップ●広径:200μL●960本(10ラック,滅菌済,フィルター)●※

その他の計測用具
●ラック入りピペットチップ●試験管、長いバイアル、100mm管などの細長い容器に最適●LTSチップ●スペシャリティLTSチップ(リムーバブルカバーラック入)ロングチップ102mm●1000μL●768本(8ラック,滅菌済,フィルター)...

温湿度計
JANコード 4974425801121・質量 9g・コード:102-5740 ・品目:SKL700RT1SK-L7...
この商品で絞り込む

その他の計測用具
商品説明【特長】●海水、熱温水、蒸気等に長期にわたり耐え、腐食の少ない安定した材質です。【仕様】●品番:RT1-1/4x3/4●中心から端面までの距離L1(mm):38●中心から端面までの距離L2(mm):40...
その他の計測用具
【アズワン AS ONE】分析・特殊機器 分離・分析ロシ 分析機器その他 ●日本薬局方の微生物限度試験など用で、常温保存で6か月の有効期限です。 ●中和剤としてレシチン、ポリソルベートが含有されてます。 商品の仕様 ●生培地 ●3局対応
この商品で絞り込む

その他の計測用具
商品説明【特長】●海水、熱温水、蒸気等に長期にわたり耐え、腐食の少ない安定した材質です。【仕様】●品番:RT1/2x1/4●中心から端面までの距離L1(mm):20●中心から端面までの距離L2(mm):22●外径(mm)D1:27...

温湿度計
【アズワン AS ONE】実験室設備 工具類 工具、道具 商品の仕様 ●仕様:右ねじ ●ねじサイズ(mm):M10×55 ●全長(mm):106 ●材質:ステンレス(SUS316) ●耐食、耐久性に優れたSUS316製 【※ご注意くだ...

墨つぼ・チョーク・マーカー
在庫状況:お取り寄せ(詳しくはこちらをクリック) ※こちらの商品はメーカー直送品となります。※こちらの商品は代引きでのお取り扱いはできません。ご入金確認後のお手配です。
計測用具カテゴリで検索されているキーワード:
お探しの商品はみつかりましたか?
検索条件の変更
ご利用前にお読み下さい
- ※ ご購入の前には必ずショップで最新情報をご確認下さい
- ※ 「掲載情報のご利用にあたって」を必ずご確認ください
- ※ 掲載している価格やスペック・付属品・画像など全ての情報は、万全の保証をいたしかねます。あらかじめご了承ください。
- ※ 各ショップの価格や在庫状況は常に変動しています。購入を検討する場合は、最新の情報を必ずご確認下さい。
- ※ ご購入の前には必ずショップのWebサイトで価格・利用規定等をご確認下さい。
- ※ 掲載しているスペック情報は万全な保証をいたしかねます。実際に購入を検討する場合は、必ず各メーカーへご確認ください。
- ※ ご購入の前にネット通販の注意点をご一読ください。
- ※ 本ページでは掲載するECサイトやメーカー等から購入実績などに基づいて手数料を受領しています。
- RT-1
- DIY・工具
- 計測用具の通販情報・価格比較
- 価格.com
© Kakaku.com, Inc. All Rights Reserved. 無断転載禁止


